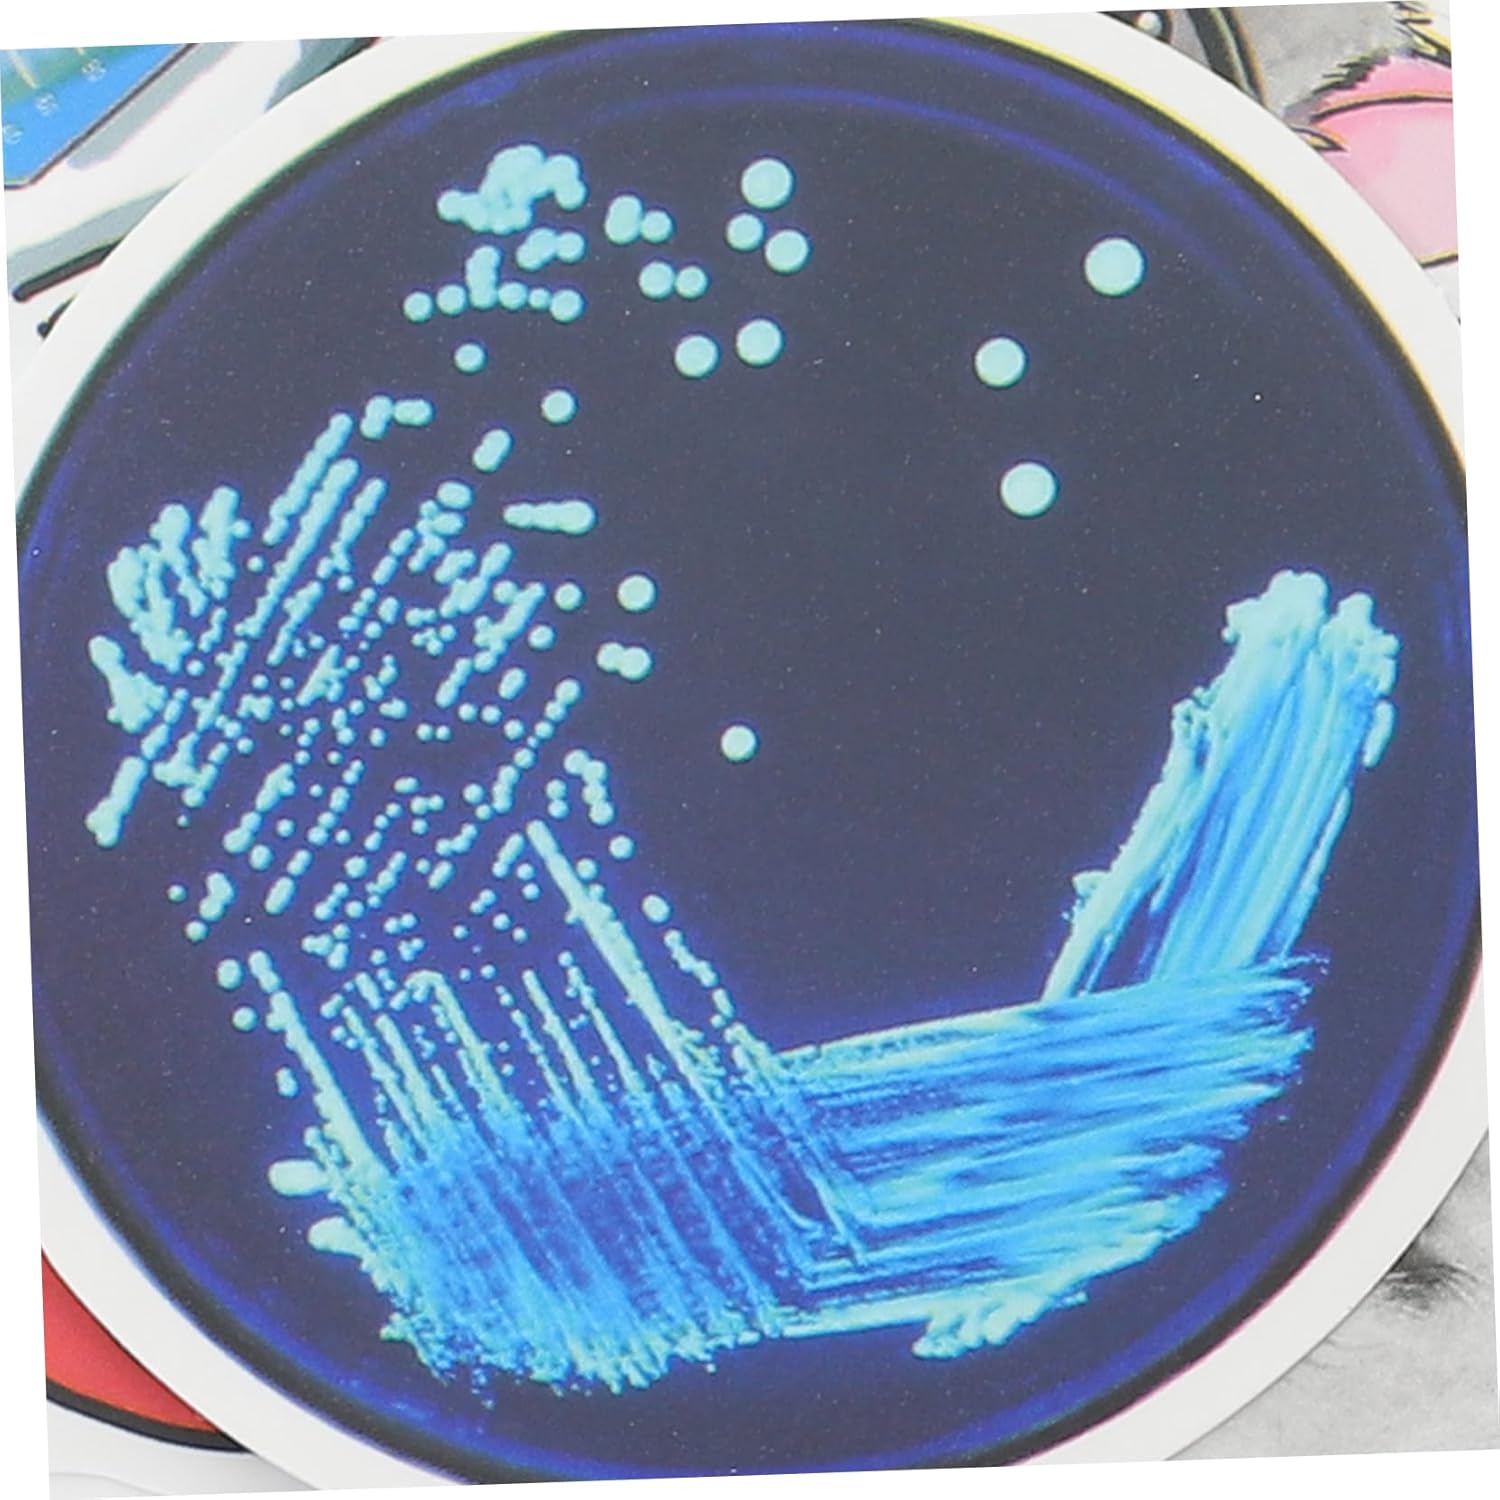

Brand:
Decorazione scientifica: il modello unico è molto attraente, ti porta buon umore e una sensazione diversa, adesivi scientifici per quaderni Adesivi scientifici decorativi: modelli chic, unici e interessanti, leggeri e portatili, molto comodi da trasportare, diario di adesivi scientifici Adesivi scientifici: possono essere applicati su laptop, valigia, computer, diario, valigia e qualsiasi cosa tu voglia, adesivo per custodia da viaggio Adesivi matematica e scienza: sono molto adatti per album di ritagli, diari, adesivi per libri di testo e adesivi decorativi, adesivi scientifici Adesivi per scrapbooking: fatti di carta, l'adesivo scientifico è sicuro da usare, adesivi per esperimenti scientifici
| Couleur | Couleurs Assorties |
| Dimensions du produit (L x l x h) | 6,3 x 5,5 x 0,1 cm; 41 grammes |
| Disponibilité des pièces détachées | Information indisponible sur les pièces détachées |
| Marque | YARNOW |
| Numéro de modèle | 26T301HD220L |
| Poids de l'article | 41 g |
